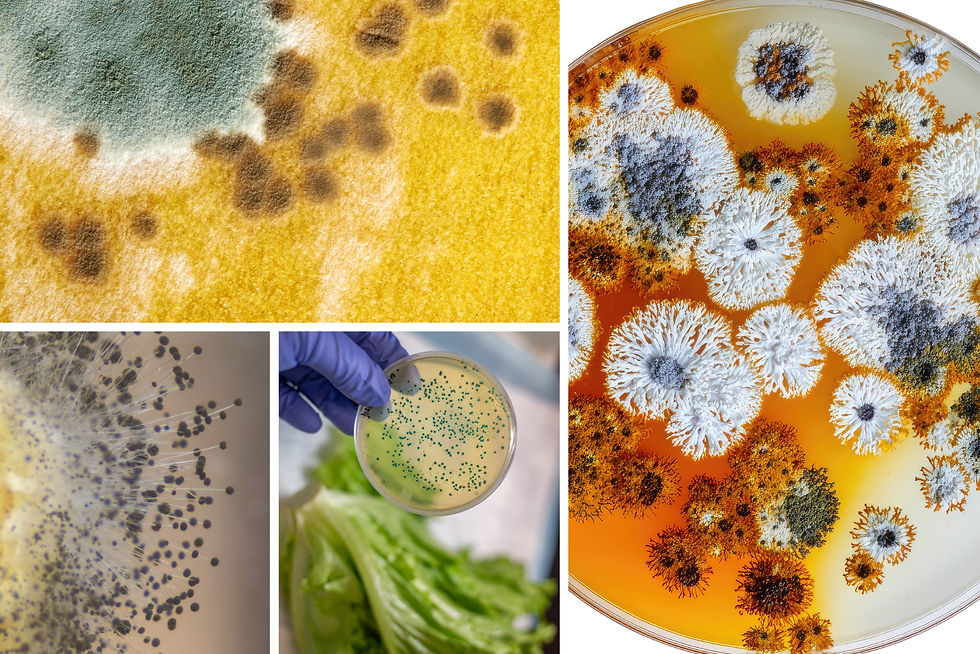
Supporting Digestive Gut Health Through Balanced Nutrition: Food Contamination & Mold Residue Risks How Food Contamination and Mold Residue Impact Digestion and Healthy Gut

Cause and Effects of Sugar: Emotional and Psychological Impacts on Mental Instability, Brain Chemistry, Glucose Levels Impacting Mood by Dietary
- Nisa Pasha

- Nov 26
- 4 min read
Updated: 3 days ago
Listen and Read Along

Created, and published By Nisa Pasha — Executive Political Health Guru, Peer Counselor, and Educator, MentalHealthRevival.org
Cause and Effects of Sugar: Emotional and Psychological Impacts on Mental Instability, Brain Chemistry, Glucose Levels Impacting Mood by Dietary
Informative, Descriptive Response on Sugar
Sugar is one of the most profound yet overlooked impacts on mental health, emotional balance, and cognitive functioning.
Sugar—especially refined sugar, sweetened drinks, processed snacks, and high-fructose corn syrup—creates a rapid rise and fall of blood glucose that disrupts the body’s natural rhythm, leading to immediate and long-term cause-and-effect consequences across the mind, gut, and appearance. The initial sugar spike overstimulates the brain, causing temporary energy followed by a crash that produces brain fog, irritability, anxiety, and difficulty focusing, which often feels like emotional instability or worsening mental illness.
These fluctuations are early warning signs, along with cravings, headaches, fatigue, mood swings, breakouts, bloating, and restless sleep. In the gut, sugar feeds harmful bacteria and causes microbial imbalance, leading to gas, inflammation, constipation, diarrhea, and increased sensitivity or intolerance. Because the gut and brain communicate constantly, sugar-driven gut disruption intensifies mental symptoms, heightening stress responses, emotional reactivity, and decision-making impairment, especially for individuals on or off psychiatric medication. On the surface, sugar affects appearance by contributing to acne, puffiness, premature aging, uneven skin tone, and water retention, all signs of internal inflammation. Eliminating or significantly reducing sugar provides measurable benefits: clearer, brighter skin; reduced puffiness; more consistent mood; improved cognitive clarity; sharper decision-making; calmer digestion; balanced energy; and a more stable emotional baseline. Over time, removing sugar helps restore gut health, strengthen mental resilience, and promote a visibly healthier, more radiant appearance, demonstrating how diet directly influences mental health and overall wellness.
1. How Sugar Disrupts Brain Chemistry
When sugar enters the bloodstream, it triggers a rapid rise in glucose. The brain, which depends on glucose to function, responds instantly—but this reaction is unregulated and unstable. The initial spike gives a temporary sensation of heightened alertness, quick energy, or emotional relief. However, this is quickly followed by an abrupt crash when insulin floods the bloodstream to remove the excess glucose.
This crash leads to:
Brain fog
Mental fatigue
Reduced concentration
Difficulty processing information
Impulsive or emotionally reactive thinking
This cycle often feels like a sudden shift in mood or “short-circuiting” of the mind, even though it is physiologically driven.
2. Emotional and Psychological Effects
Sugar stimulates the release of dopamine, the same neurotransmitter involved in pleasure, reward, and addictive behaviors. Over time, this rewires emotional responses and increases sensitivity to stress.
This can appear as:
Increased irritability or emotional volatility
Heightened anxiety
More intense emotional responses to minor triggers
Difficulty accessing logical thought during stress
Emotional “hangovers” after sugar crashes
For individuals with trauma histories, PTSD symptoms, mood disorders, or chronic stress, sugar can magnify emotional sensitivity and decrease resilience, creating deeper emotional lows after the artificial high wears off.
3. Impact on Mental Health Symptoms
Sugar can mimic, worsen, or amplify symptoms associated with:
Depression: causes inflammatory responses that blunt motivation, pleasure, and mood regulation
Anxiety: fuels adrenaline surges, restlessness, and nervousness
ADHD: interferes with attention, impulse control, and executive functioning
Bipolar or mood instability: intensifies highs and deepens lows
Trauma responses: increases reactivity, hypervigilance, and difficulty calming the mind
Because sugar affects both the central nervous system and the gut-brain axis, its psychological effects are powerful and often misinterpreted as “mental illness worsening,” when the true cause is metabolic imbalance.
4. Decision-Making on Psychiatric Medication
Sugar can interfere with medication effectiveness by destabilizing internal rhythms that medications are designed to support.
For people taking psychiatric medications, sugar can cause:
Emotional instability despite being medicated
Intensified side effects such as fatigue or irritability
Difficulty recognizing whether symptoms are medication-related or sugar-related
Faster energy crashes that feel like medication “wearing off”
Impulsive decision-making or struggle with motivation
In many cases, individuals believe their medication is failing, when the real issue is sugar-induced biochemical fluctuations.
5. Decision-Making Off Medication
Without medication support, sugar becomes even more destabilizing.
It reduces the brain’s capacity for:
Rational thinking
Risk assessment
Emotional regulation
Consequence-based decision-making
Patience and cognitive flexibility
Sugar-driven highs followed by lows can mimic symptoms of impulsivity, mania-like energy, depression, or anxiety, creating confusion about what a person is truly feeling emotionally vs. what is chemically triggered.
6. Gut Health and the Gut-Brain Connection
Sugar feeds yeast, harmful bacteria, and inflammatory responses in the digestive system.
A disrupted gut microbiome influences:
Mood regulation
Sleep patterns
Hormonal balance
Memory and focus
Stress tolerance
Because 90% of serotonin is produced in the gut, sugar-induced gut imbalance can directly create emotional instability, low motivation, irritability, and chronic fatigue.
7. Long-Term Impact on Wellness
Over time, chronic sugar intake contributes to systemic inflammation that affects every dimension of wellness:
Physical: weight gain, tiredness, headaches, joint pain
Emotional: irritability, mood crashes, low stress tolerance
Cognitive: poor clarity, slow thinking, impulsive decisions
Spiritual: reduced grounding, emotional heaviness
Social: decreased patience, increased sensitivity to conflict
keywords: sugar, sugar brain, glucose, mood and dietary, mental instability,
"In marginalized communities, where sugar-heavy diets are normalized or affordable, the psychological consequences are often mislabeled as behavioral problems, noncompliance, or mental instability rather than dietary-driven chemical imbalance."
Summary
Sugar is not just a dietary ingredient—it is a biochemical disruptor that affects mood, behavior, thought patterns, impulse control, trauma responses, and the effectiveness of psychiatric medications. Its impact is especially pronounced in individuals navigating mental illness, trauma, stress, or challenging environments. Reducing sugar intake provides immediate and long-term benefits, including clearer thinking, emotional stability, better decision-making, and a calmer nervous system. If you have specific questions or concerns, feel free to share!
Hope you found this insightful while grasping the key components!
Please contact me if you would like to chat in a peer counseling session, revolving around this post or another topic.
Mental health revival seeking to inspire a unique perception of mental health awareness

Comments